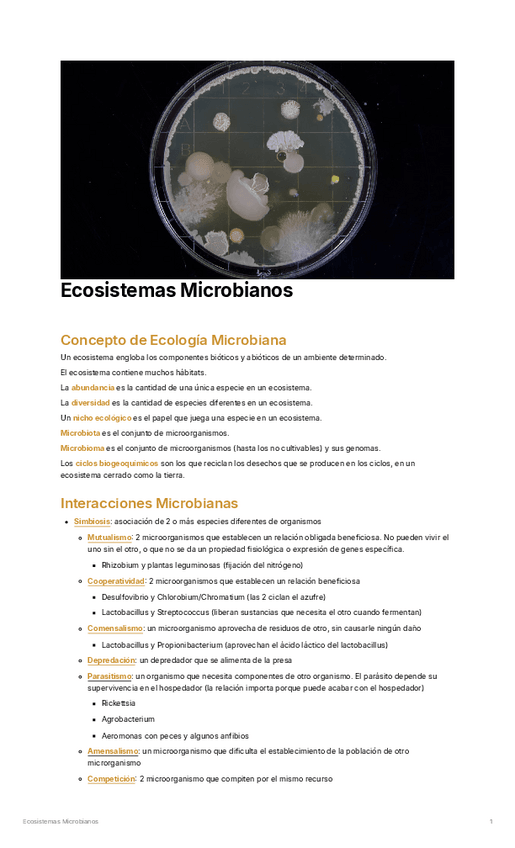

Introduccion-a-la-Microbiologia.pdf
3 páginas

Microscopia.pdf
8 páginas

Estructura-y-Funcion-de-la-Celula-Procariota.pdf
13 páginas

Crecimiento-Microbiano.pdf
7 páginas

Control-de-Crecimiento-Microbiano.pdf
9 páginas

Genetica-Bacteriana.pdf
17 páginas

Metabolismo-y-Obtencion-de-Energia.pdf
11 páginas

Clasificacion-y-Filogenia-de-los-Microorganismos.pdf
7 páginas

Virologia.pdf
6 páginas

Proteobacterias-No-Fermentadoras.pdf
6 páginas

Procariotas-Anaerobias-Facultativas-y-Obligadas.pdf
8 páginas

Bacterias-Gram.pdf
12 páginas

Arqueas.pdf
4 páginas

Hongos.pdf
6 páginas
Ecosistemas-Microbianos.pdf
13 páginas

Microbiologia-Industrial-y-Biotecnologia-Microbiana.pdf
4 páginas
content_copy